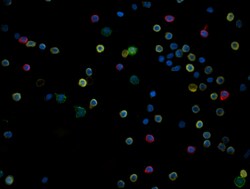
Biolegend Alexa Fluor 594 anti-human CD20, Quantity: Each of 1

Learn More
Biolegend Alexa Fluor 594 anti-human CD20
Supplier: Biolegend 302354

Alexa Fluor 594 anti-human CD20 [2H7]; Isotype: Mouse IgG2b, κ; Reactivity: Human, Baboon, Capuchin Monkey, Chimpanzee, Cynomolgus, Pigtailed Macaque, Rhesus, Squirrel Monkey; Apps: ICC, IHC-F; Size: 100 ug
By clicking Submit, you acknowledge that you may be contacted by Fisher Scientific in regards to the feedback you have provided in this form. We will not share your information for any other purposes. All contact information provided shall also be maintained in accordance with our Privacy Policy.